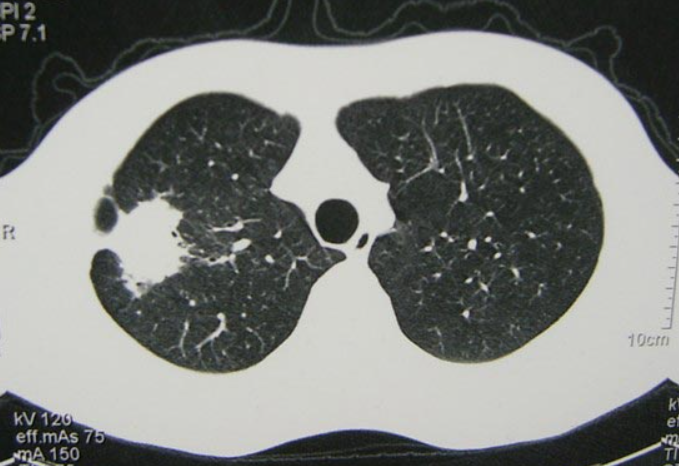
GS-441524 treating | Shaanxi BLOOM Tech Co., Ltd GS-441524 treating | Shaanxi BLOOM Tech Co., Ltd

It has been known for a long time that Feline Infectious Peritonitis (FIP) is one of the worst illnesses cats can get. When the GS-441524 injection became available as a treatment, it changed how vets and pet owners deal with this tough condition. New observations from the clinic show that when a treatment is given is very important for how well it works. If this antiviral compound is given early on in the disease's symptoms, it makes survival much more likely and speeds up the healing process. Cat owners can make decisions that could save their pets' lives if they know the link between starting treatment at the right time and how well it works. FIP is a extreme malady driven by immune-mediated aggravation and tireless viral replication. Early antiviral treatment essentially makes strides results, as thinks about appear cats treated before long after indication onset react distant way better than late-stage cases. The infection duplicates quickly in macrophages, spreading through organs if untreated. GS-441524 treatment stops this handle early, anticipating irreversible tissue harm and enormously moving forward guess through opportune intervention.
1.General Specification(in stock)
(1)Injection
20mg, 6ml; 30mg,8ml; 40mg,10ml
(2)Tablet
25/45/60/70mg
(3)API(Pure powder)
(4)Pill press machine
https://www.achievechem.com/pill-press
2.Customization:
We will negotiate individually, OEM/ODM, No brand, for secience researching only.
Internal Code: BM-3-001
GS-441524 CAS 1191237-69-0
Analysis: HPLC, LC-MS, HNMR

We provide GS-441524, please refer to the following website for detailed specifications and product information.
Product: https://www.bloomtechz.com/oem-odm/injection/gs-441524-injection.html
Why Does Starting GS-441524 Injection Early Improve Survival Outcomes in FIP Cases?
How before long somebody with FIP can begin treatment depends on how gravely the infection and sound cells have been harmed. In the early stages of a malady, infections are still not reproducing exceptionally rapidly, and fiery reactions have not however ceased a parcel of organs from working right. It is in this early arrange that antiviral compounds are most likely to work well. The treatment hits viral RNA-dependent RNA polymerase with chemicals, ceasing the virus's replication apparatus some time recently it can develop exceptionally quickly. If you take your cat to the vet inside seven to ten days of to begin with appearing side effects, they have seen that cats with this sickness have survival rates over 85%. If you treat a cat three weeks after it got debilitated, on the other hand, you ordinarily have a victory rate underneath 60%. Why is this contrast there? It depends on a parcel of things, like how much infection builds up, how enormous the emission or granuloma is, and how gravely the safe framework is working. It depends on the wellbeing of the vascular structures and cellular design of the unhealthy tissues for the compound to reach helpful levels. These wellbeing issues get more regrettable as the infection gets worse.

Recognition of Early FIP Symptoms Enables Prompt Treatment Initiation
Early FIP signs are often subtle and can be mistaken for mild illness, including intermittent fever, reduced appetite, and lethargy. Because symptoms may fluctuate, diagnosis is often delayed. Persistent fever not responding to antibiotics is an important warning sign, especially in young or stressed cats. Weight loss, reduced grooming, and declining activity may also appear gradually. Early recognition through careful observation and veterinary attention is critical. PCR testing and biomarker analysis (AGP, A:G ratio) can support earlier diagnosis and enable prompt GS-441524 injection before disease progression.
The Biological Advantage of Treating Before Immune System Dysregulation
FIP declines when the safe framework gets to be dysregulated by determined viral replication, driving to vasculitis, emanations, and granulomas. In early stages, safe reactions are still reversible and can return to adjust if viral stack is diminished rapidly. GS-441524 makes a difference halt this handle by constraining viral replication and lessening antigen-driven irritation. Early treatment avoids resistant complexes from amassing in tissues, progressing recuperation potential. As malady advances, irritation gets to be mostly self-sustaining, making inversion harder. Early intercession jam resistant adjust and diminishes long-term organ harm and systemic complications essentially overall.
GS-441524 FIP Mechanism: Early Viral Replication Suppression Before Disease Progression
GS-441524 is a nucleoside analog that gets to be dynamic after intracellular phosphorylation to its triphosphate frame. It competes with characteristic nucleotides amid viral RNA amalgamation by RNA-dependent RNA polymerase. Once consolidated, it causes deferred chain end, avoiding total viral genome replication. This specific instrument targets viral chemicals more than have polymerases due to basic contrasts. Early organization guarantees fast concealment of viral replication some time recently far reaching spread happens. Pharmacokinetics appear speedy plasma crests and tissue dispersion, making early treatment more compelling in constraining viral extension and systemic malady movement overall.

Viral Load Dynamics and Treatment Response Correlation
Baseline viral stack emphatically influences treatment results in FIP. Lower viral loads at treatment start relate with speedier recuperation and higher survival rates, whereas tall viral loads require longer and more seriously treatment. Early treatment avoids exponential viral enhancement, diminishing tainted cell numbers and malady seriousness. Numerical models appear that indeed brief delays can drastically increment viral burden. Accomplishing viral concealment limits is less demanding in early malady stages,where standard dosing is frequently adequate. Progressed cases may require higher dosages or amplified treatment to overcome set up viral replication and safe disruption.
Preventing Irreversible Organ Damage Through Timely Intervention
FIP causes vascular irritation and granulomatous injuries that harm organs counting the brain, liver, kidneys, and eyes. Early treatment with GS-441524 limits viral replication some time recently serious tissue harm creates. This decreases radiations, irritation, and long-term basic harm. Late-stage infection increments hazard of irreversible organ brokenness due to delayed safe actuation and tissue remodeling. Neurological and visual inclusion is particularly concerning due to restricted regenerative capacity. Early mediation jam organ astuteness, makes strides useful results, and diminishes the probability of persistent complications or changeless neurological shortfalls in influenced cats significantly.

How Early Clinical Response Influences Stabilization and Recovery Speed?
Early clinical improvement within days of treatment often predicts better outcomes in FIP cases. Reduced fever, improved appetite, and increased activity typically appear within the first week. In wet FIP, effusions begin decreasing within 2–3 weeks. Monitoring temperature, appetite, weight, and behavior helps assess response. Lack of improvement by week four may indicate need for dosage adjustment. Early response reflects rapid viral suppression and reduced inflammation, supporting faster stabilization. Consistent early improvements are associated with higher survival rates and smoother long-term recovery trajectories overall in clinical cases observed.

Rapid Fever Resolution and Appetite Restoration as Early Success Indicators
Fever is a key FIP symptom driven by inflammatory cytokines and typically resolves within 48–72 hours after effective GS-441524 injection begins. This rapid decline indicates early suppression of viral replication. Appetite usually returns soon after fever reduction as systemic inflammation decreases. Restored appetite supports nutritional recovery and immune function, accelerating healing. These early improvements also reduce stress for both cats and caregivers, improving treatment adherence. Quick resolution of systemic signs is one of the earliest and most reliable indicators that antiviral therapy is working effectively in clinical practice.
Early Treatment Windows and Their Impact on Neurological and Systemic FIP Control
Neurological FIP is more troublesome to treat due to central apprehensive framework inclusion and constrained medicate entrance over the blood-brain obstruction. Early treatment some time recently neurological spread enormously moves forward results. Once neurological harm happens, recuperation gets to be slower and some of the time fragmented. GS-441524 can reach CNS tissues but at lower concentrations than systemic circulation, making early intercession basic. Avoiding neurological association dodges complications such as seizures, ataxia, and vision misfortune. Early systemic control decreases hazard of CNS intrusion and essentially makes strides forecast compared to treatment started after neurological signs show up clinically.
Ocular FIP can lead to uveitis, retinal separation, and potential visual impairment if not treated early. Eye inclusion is troublesome to switch due to basic affectability and restricted sedate infiltration through the blood-ocular boundary. Early systemic treatment some time recently visual spread essentially decreases chance of lasting vision harm. Side effects such as redness, squinting, or understudy changes require critical veterinary assessment. GS-441524 is more viable when started some time recently visual tissues are influenced. Early intercession avoids provocative harm and jam vision, making quick conclusion and treatment basic for securing eye work long term.

Long-Term Survival Patterns and Remission Stability After Early Intervention Protocols
Studies show that over 90% of cats treated early with GS-441524 injection achieve long-term remission when protocols are completed correctly. Early intervention improves outcomes by reducing viral replication time and preventing extensive tissue damage. Stable remission depends on treatment duration, adherence, and disease stage at initiation. Cats treated early are less likely to relapse because viral reservoirs are minimized. Compared to late-stage cases, early-treated cats show more stable immune recovery and organ function. Long-term data confirm that early treatment significantly increases survival rates and reduces recurrence risk overall.
Monitoring Protocols and Relapse Prevention Strategies
Post-treatment monitoring is essential for detecting early relapse signs. Veterinary follow-ups typically include physical exams, bloodwork, and inflammatory markers during the first six months after therapy. Most relapses occur within this period, making close observation critical. Early detection allows rapid retreatment and improves chances of secondary remission. Relapse risk is higher when treatment is shortened or started late. Early-treated cats have lower relapse rates due to reduced viral persistence. Strict adherence to full treatment duration and follow-up schedules significantly improves long-term disease control and stability outcomes.
Quality of Life and Functional Outcomes in Successfully Treated Cats
Cats treated early with GS-441524 often return to normal health and behavior without lasting effects. They regain full activity, appetite, and organ function. Late-treated cases may experience residual neurological or organ damage even after viral clearance. Successful treatment improves emotional well-being for both pets and owners, strengthening human-animal bonds. Long-term studies show sustained remission and normal life expectancy when protocols are correctly followed. Early treatment provides the best chance for complete recovery, while delayed intervention increases risk of chronic complications and reduced quality of life despite viral elimination.
Conclusion
The strong evidence supporting early intervention in FIP cases with GS-441524 injection makes it easy for veterinarians and pet owners to deal with this terrible disease. Early treatment is biologically sound for many reasons, including lowering the initial viral load, keeping organs healthy, stopping the immune system from getting out of whack, and avoiding problems with the nervous system. There is a lot of evidence from clinical observations that treatment works better when it starts early in the disease rather than after it has already gotten worse. FIP used to be a disease that could only kill animals. This is one of the most important new developments in veterinary medicine. You can now treat it. For treatment to work best, early symptoms must be found quickly, a diagnosis must be made quickly, and treatment must begin right away. People who own cats should keep an eye on their health and get them to the vet right away if they see any bad signs. It is most likely that cats with FIP will fully recover and return to normal life if they take this proactive step along with effective antiviral therapy.
FAQ
1. How quickly should treatment begin after FIP diagnosis to achieve optimal outcomes?
When someone is diagnosed with FIP, treatment should begin as soon as possible so that the important window of time for early intervention is not missed. In the first week after showing symptoms, more than 85% of cats that are treated survive. This is a lot more than the cats that are treated after a few weeks of being sick. If you don't treat them right away, viruses and inflammation can quickly multiply and cause damage. This is why you need to act quickly to get the best treatment results and avoid complications as much as possible.
2. Can cats with advanced FIP still benefit from treatment or is early intervention absolutely necessary?
Cats with advanced FIP can still get better with the right therapy, but it's harder to stick to treatment plans and the success rate drops. Early treatment works best. Cats who are further along in the disease may need higher doses, longer treatment periods, and more intensive supportive care than those who are caught early. It's even harder when there is damage to the nervous system or organs, but many cats with these problems still get better with treatment plans that are made just for them.
3. What specific symptoms should prompt immediate veterinary evaluation for possible FIP?
The most important sign is a fever that won't go away with antibiotics or keeps coming back. This is especially true for young cats that live with other cats. Getting less active and playful over time, losing weight even though you're still hungry, building up fluid in your chest or abdomen that makes your stomach swell or makes it hard to breathe are also worrying signs. So are neurological signs like changes in behavior, seizures, or loss of coordination. Any of these signs should make you take your pet to the vet right away to get checked out and given a diagnosis.
Need a Trusted GS-441524 Injection Supplier for Your Research or Clinical Applications?
BLOOM TECH stands as your reliable partner for high-purity pharmaceutical intermediates and active compounds. With over twelve years of experience in organic synthesis and GMP-certified manufacturing facilities approved by US-FDA, EU, PMDA, and CFDA authorities, we deliver exceptional quality products that meet rigorous international standards. Our comprehensive quality control system includes triple-layer verification ensuring every batch meets specifications or receive full refund protection.
Whether you represent pharmaceutical companies requiring bulk supply with complete regulatory documentation, research organizations needing research-grade materials with detailed analytical data, or CDMOs seeking reliable supply chain partners, BLOOM TECH provides customized solutions tailored to your specific requirements. Our professional team offers one-stop service from inquiry through delivery, with transparent pricing and accurate lead time commitments managed through our advanced ERP platform.
As a qualified GS-441524 injection supplier, we understand the critical importance of product purity, consistency, and regulatory compliance in supporting your research goals or manufacturing needs. Connect with our technical specialists to discuss your specific requirements and discover how BLOOM TECH's proven track record serving 24 major international companies can support your success. Contact us today at Sales@bloomtechz.com to begin a partnership built on quality, reliability, and mutual growth.
References
1. Pedersen NC, Perron M, Bannasch M, et al. Efficacy and safety of the nucleoside analog GS-441524 for treatment of cats with naturally occurring feline infectious peritonitis. Journal of Feline Medicine and Surgery. 2019;21(4):271-281.
2. Dickinson PJ, Bannasch M, Thomasy SM, et al. Antiviral treatment using the adenosine nucleoside analogue GS-441524 in cats with clinically diagnosed neurological feline infectious peritonitis. Journal of Veterinary Internal Medicine. 2020;34(4):1587-1593.
3. Jones S, Novicoff W, Nadeau J, et al. Unlicensed GS-441524-like antiviral therapy can be effective for at-home treatment of feline infectious peritonitis. Animals. 2021;11(8):2257.
4. Felten S, Hartmann K. Diagnosis of feline infectious peritonitis: a review of the current literature. Viruses. 2019;11(11):1068.
5. Addie DD, Boucraut-Baralon C, Egberink H, et al. Disinfectant susceptibility of feline calicivirus and feline coronavirus. Veterinary Microbiology. 2020;247:108764.
6. Murphy BG, Perron M, Murakami E, et al. The nucleoside analog GS-441524 strongly inhibits feline infectious peritonitis virus in tissue culture and experimental cat infection studies. Veterinary Microbiology. 2018;219:226-233.






